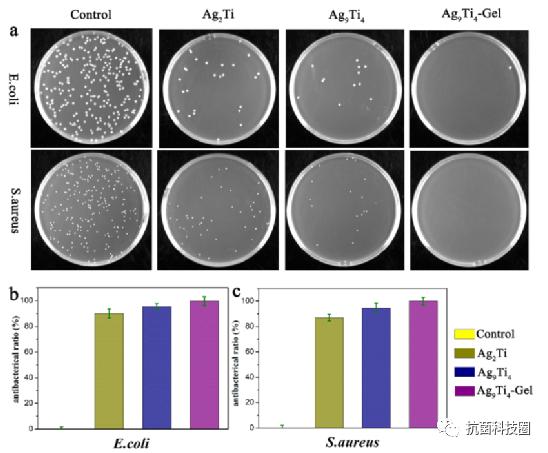
【科研快报】具有抗菌、光热和稳定的银钛氧簇水凝胶用于伤口愈合

第一作者:Wen Luo
通讯作者:Yupeng Shi, Xingchen Li, Lin Jin
通讯单位:周口师范学院
研究速览:
近期,周口师范学院靳林教授等人在Materials & Design上共同发表了专为伤口愈合设计的抗菌、光热和稳定的银钛氧簇水凝胶的研究工作。钛氧簇(TOCs)由于其精确、可调的结构和丰富的性质,已被广泛应用于许多领域。然而,由于TOCs自身性能的影响,如结构不稳定、缺乏作为生物医用材料所需的抗菌和抗炎特性等,TOCs在生物医学领域的应用受到很大限制。在这项工作中,该作者通过引入银和水杨酸,一步溶剂热法制备了一种活性位点为Ag和水杨酸的新型的银-钛氧簇(Ag-TOC, Ag9Ti4),该簇具有稳定、优良的抗菌和抗炎性能。此外,体内结果表明Ag9Ti4水凝胶系统在近红外条件下表现出更好的抗炎和伤口愈合能力。结合其优异的性能,构建抗菌、光热和稳定的Ag-TOC水凝胶体系可以为扩大TOCs的生物医学应用提供新的策略。

(a) Ag2Ti、Ag9Ti4、Ag9Ti4水凝胶的制备方案。(b) 近红外作用下复合水凝胶对伤口愈合的影响。
要点分析:
要点一:
Ag9Ti4-Gel的结构特性。 氧化钛团簇(TOCs)作为氧化钛材料的一种,具有尺度均匀、结构精确的特点,是一种发展迅速的分子材料,特别是在生物医学领域出现并显示出良好的应用前景,如生物发光成像、光动力治疗、抗菌等。
要点二:
Ag9Ti4-Gel的抗菌性能 。Ag9Ti4-Gel的加热行为可以通过近红外曝光远程重复控制,而且Ag9Ti4-Gel具有良好的体内加热性能。在PVA/PDA水凝胶基质与Ag9Ti4的协同作用下,所设计的Ag9Ti4-Gel体系具有较强的抑菌活性。这进一步验证了Ag9Ti4水凝胶在有效抗菌治疗方面的巨大潜力。
图文导读

图1. Ag9Ti4和Ag2Ti化合物的晶体结构。(a) 为清晰起见,省略了Ag9Ti4簇、H原子的分子结构;(b) Ag9Ti4核心结构(左),Ag9Ti4团簇结构(右),每个Ti原子的配位多面体以多面体模式显示;(c) Ag2Ti的重复单元结构和Ag2Ti的一维结构(d),原子色码:天蓝色Ti;紫Ag;红O;蓝色N;灰色C;(e) Ag9Ti4的PXRD谱。(f) Ag2Ti, Ag9Ti4和溶解在DMSO中的SA本身的紫外-可见-近红外光谱,插入显示Ag2Ti(左)和Ag9Ti4(右)溶液的颜色。

图2. 水凝胶的表征。(a-c) SEM对水凝胶(对照,Ag2Ti, Ag9Ti4水凝胶)的结构分析。(d) 对照、Ag2Ti和Ag9Ti4水凝胶前后的照片;(e,f) 对照Ag2Ti和Ag9Ti4水凝胶的FTIR和PXRD谱;(g,f) Ag9Ti4-Gel粘附在不同基质和生物组织上的照片。

图3. Ag2Ti-Gel和Ag9Ti4-Gel的光热转化(Ag2Ti和Ag9Ti4的质量均为1 mg)。Ag2Ti-Gel和Ag9Ti4-Gel在0.33 W、0.50 W和1.0 W近红外光照下的温升曲线(a)。Ag2Ti-Gel (b)和Ag9Ti4-Gel (c)在5个开/关周期内的温度变化。(d-f) Ag9Ti4-Gel组在近红外照射下的热像,近红外功率为0.33 W。
图4. Ag2Ti、Ag9Ti4和Ag9Ti4-Gel组的抑菌活性:(a) 定殖,(b,c) PBS、Ag2Ti、Ag9Ti4和Ag9Ti4-Gel处理后金黄色葡萄球菌和大肠杆菌的抑菌效率量化。

图5. Ag9Ti4-Gel对大鼠创面愈合的影响。(a) 各组(对照组、Gel组、Ag9Ti4-Gel组、Ag9Ti4-Gel + NIR组)皮肤创面在第0、1、3、5、8、12天的代表性照片。(b) 对照组、Gel组、Ag9Ti4-Gel组、Ag9Ti4-Gel + NIR组覆盖创面的组织学评价。(c) 第0、1、3、5、8、10、12天不同处理的创面收缩示意图。(d) 第12天对创面进行相应的H&E染色。

图6. (a) INR照射/非NIR照射Ag9Ti4-Gel、Gel和对照组的CD31、VEGF、TGF-b和IL-6免疫组化染色。(b-e) 不同组染*图色**像定量分析:疤痕宽度、college沉积、CD31、VEGF、TGF-b和IL-6。
结论
综上所述,该作者成功制备了一种新型稳定的Ag-TOC水凝胶(Ag9Ti4-Gel),具有抗菌和光热性能,并在小鼠皮肤伤口中表现出优异的愈合能力。结果表明,AgTOCs不仅能破坏PVA/PDA凝胶网络的稳定,还能通过分子簇的存在降低银离子的细胞毒性,使Ag9Ti4-Gel在近红外下具有光热和抗菌性能。此外,AgTOCs水凝胶可以促进小鼠血管生成,加速伤口愈合。Ag9Ti4-Gel的构建提供了一种制备近红外响应复合材料的新方法,并可能作为一种治疗愈合伤口的新型敷料。
全文链接: https://doi.org/10.1016/j.matdes.2023.111674
参考文献: Wen Luo, Bin Hu, Hua-Li Zhang, Chunyang Li, Yupeng Shi, Xingchen Li, Lin Jin. Antibacterial, photothermal and stable Ag-titanium-oxo-clusters hydrogel designed for wound healing. Materials & Design . 2023.
doi: 10.1016/j.matdes.2023.111674